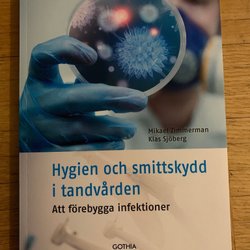

Ending time8 Apr 19:56.
Price:SEK 99,Starting price.
Ending time24 May 19:48.
Price:SEK 80,Buy now.
Ending time24 May 19:47.
Price:SEK 80,Buy now.
Ending time8 Apr 20:41.
Price:SEK 199,Starting price.
Ending time8 Apr 21:19.
Price:SEK 99,Starting price.
Ending time24 May 14:34.
Price:SEK 80,Buy now.
Ending time24 May 13:37.
Price:SEK 99,Buy now.
Ending time24 May 13:05.
Price:SEK 399,Buy now.
Ending time7 Apr 18:46.
Price:SEK 15,Starting price.
Ending time7 Apr 18:46.
Price:SEK 10,Starting price.
Ending time7 Apr 18:26.
Price:SEK 10,Starting price.
Ending time24 May 05:04.
Price:SEK 20,Buy now.
Ending time24 May 05:02.
Price:SEK 20,Buy now.
Ending time6 Apr 22:11.
Price:SEK 100,Or Buy now SEK 150,.
Ending time6 Apr 22:10.
Price:SEK 78,Or Buy now SEK 83,.
Ending time23 May 20:31.
Price:SEK 150,Buy now.
Ending time23 May 18:14.
Price:SEK 300,Buy now.
Ending time5 Apr 20:08.
Price:SEK 216,Starting price.
Ending time23 Apr 07:39.
Price:SEK 199,Buy now.
Ending time6 Apr 19:58.
Price:SEK 365,Or Buy now SEK 385,.
Ending time22 Apr 17:33.
Price:SEK 200,Buy now.
Ending time22 May 14:10.
Price:SEK 270,Buy now.
Ending time22 May 10:59.
Price:SEK 224,Buy now.
Ending time5 Apr 18:54.
Price:SEK 67,Starting price.
Ending time16:12 .
Price:SEK 29,Starting price.
Ending time21 May 12:58.
Price:SEK 99,Buy now.
Ending time21 May 11:48.
Price:SEK 100,Buy now.
Ending time20:11 .
Price:SEK 19,Or Buy now SEK 39,.
Ending time20:00 .
Price:SEK 50,Starting price.
Ending time17:46 .
Price:SEK 200,Starting price.
Ending time20 May 15:02.
Price:SEK 42,Buy now.
Ending time20 May 15:02.
Price:SEK 48,Buy now.
Ending time14:27 .
Price:SEK 149,Or Buy now SEK 179,.
Ending time20 Apr 12:36.
Price:SEK 80,Buy now.
Ending time11:10 .
Price:SEK 9,Starting price.
Ending time19 May 23:50.
Price:SEK 200,Buy now.
Ending time19 May 21:23.
Price:SEK 150,Buy now.
Ending time19 May 20:53.
Price:SEK 200,Buy now.
Ending time19 May 16:54.
Price:SEK 170,Buy now.
Ending time19 May 12:56.
Price:SEK 120,Buy now.
Ending time19 May 12:40.
Price:SEK 150,Buy now.
Ending time18 May 23:39.
Price:SEK 405,Buy now.
Ending time18 May 21:13.
Price:SEK 296,Buy now.
Ending time18 May 20:52.
Price:SEK 45,Buy now.
Ending time18 Apr 17:29.
Price:SEK 90,Buy now.
Ending time18 Apr 17:29.
Price:SEK 150,Buy now.
Ending time18 Apr 17:28.
Price:SEK 200,Buy now.